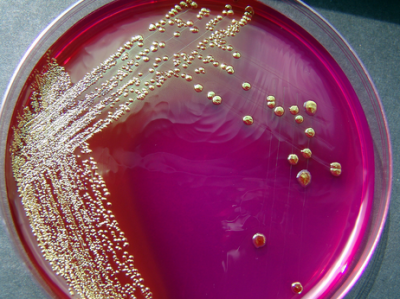

INFECCIÓN TRACTO URINARIA. MU
Concepto
Una Infección Tracto Urinaria (ITU) consiste en una inflamación del urotelio sintomática debida a la invasión microbiana caracterizada por bacteriuria y piuria. La bacteriuria implica la presencia de bacterias en la orina, la cual es normalmente estéril; en ausencia de piuria, la bacteriuria indica colonización o contaminación por gérmenes.
Epidemiología
La ITU es el tipo de infección bacteriana más común y es responsable de al menos 7 millones de visitas médicas y de unas 100 000 hospitalizaciones al año. La mayoría de las infecciones se diagnostican clínicamente basados en los síntomas y el sedimento de orina (SO). Con este algoritmo diagnóstico, sin embargo, se pierden unos 20 % de pacientes con cultivos positivos y se tratan unos 50 % que tendrán cultivos negativos.
La mayoría de infecciones de orina se producen por gérmenes de origen entérico, siendo la más frecuente la Escherichia coli.
Patogenesis
La infección del tracto urinario se produce como consecuencia de una compleja interacción entre factores de virulencia bacteriana y del deterioro de la defensa del huésped. Las vías de entrada en el tracto urinario incluyen la infección ascendente desde la uretra (como la más frecuente), la diseminación hematógena directa y la diseminación linfática.
La virulencia de la bacteria, es decir, su habilidad para causar enfermedad, aumenta la capacidad de que una infección prospere en el huésped. Para esto, es necesario que la bacteria se adhiera a las células epiteliales de la vagina y del urotelio. Algunas cepas de Echerichia coli, principal germen relacionada a ITU, expresa en su superficie una estructura a base de proteínas conocida como pili tipo I y que le proporciona una capacidad excepcional para la adherencia celular; es más existe un pili tipo P que le confiere afinidad a receptores glicolipidos del riñón, favoreciendo de este modo las infecciones renales, conocidas como pielonefritis. Aquí toman relevancia las defensas del huésped y otros gérmenes no uropatógenos que colonizan de manera comensal la vagina, la uretra y la piel parauretral proporcionando una barrera mecánica a la colonización por bacterias patógenas.
La virulencia de la bacteria, es decir, su habilidad para causar enfermedad, aumenta la capacidad de que una infección prospere en el huésped. Para esto, es necesario que la bacteria se adhiera a las células epiteliales de la vagina y del urotelio. Algunas cepas de Echerichia coli, principal germen relacionada a ITU, expresa en su superficie una estructura a base de proteínas conocida como pili tipo I y que le proporciona una capacidad excepcional para la adherencia celular; es más existe un pili tipo P que le confiere afinidad a receptores glicolipidos del riñón, favoreciendo de este modo las infecciones renales, conocidas como pielonefritis. Aquí toman relevancia las defensas del huésped y otros gérmenes no uropatógenos que colonizan de manera comensal la vagina, la uretra y la piel parauretral proporcionando una barrera mecánica a la colonización por bacterias patógenas.
 |
| Escherichia coli sp. |
Estudios recientes demuestran una predisposición genética para la adherencia bacteriana de células epiteliales en personas portadoras dea alelo HLA A3.
Otros factores asociados que aumentan el riesgo de infección se deben a patología asociada del tipo obstructivo, anomalías anatómicas, historia de litiasis, reflujo vesicoureteral, vejiga neurogena, etc.
Interpretación del uroanálisis.
El Cultivo de orina es el estándar de oro para el diagnóstico de una ITU, sin embargo, los resultados de esta prueba demoran unos 2 días para obtener el germen responsable de la infección, y alrededor de 3 días más para tener la sensibilidad antibacteriana a determinados antibióticos.
El Sedimento de Orina nos puede dar una primera aproximación diagnóstica y nos permitirá establecer un tratamiento empírico de amplio espectro.
El Sedimento de Orina como tal se basa en 2 partes:
Una son los resultados analíticos y otra la valoración microscópica de la muestra. Los resultados analíticos valoran el pH, la presencia de esterasa de leucocitos, los nitratos y la sangre.
El componente microscópico identifica las células rojas y blancas de la sangre así como los cilindros granulosos e hialinos, bacterias y levaduras.
Un SO sugerente de infección típicamente mostrara la presencia de esterasa de leucocitos, piuria (leucocitos), hematuria microscópica y bacterias. Los nitritos se presentan en infecciones por gram negativas con excepción de aquellas causadas por pseudomonas. El hallazgo de células epiteliales puede indicar contaminación por flora vaginal y será necesario repetir el estudio.
Dr. Luis Fernando Susaníbar Napurí
Madrid Urología
Urología y Medicina Sexual
PROBLEMAS UROLOGICOS?
MADRID UROLOGIA
Escribanos y le pondremos en contacto con un especialista.
Fijo: 910 32 73 74
Fijo: 910 32 73 74
email us: madridurologia@gmail.com
Próxima apertura de consultas:
Calle del Corazón de María. Prosperidad. Chamartín. Madrid
Madrid Urología
«No deje todo en manos del Dr. Google… Escribanos»
madridurologia@gmail.com